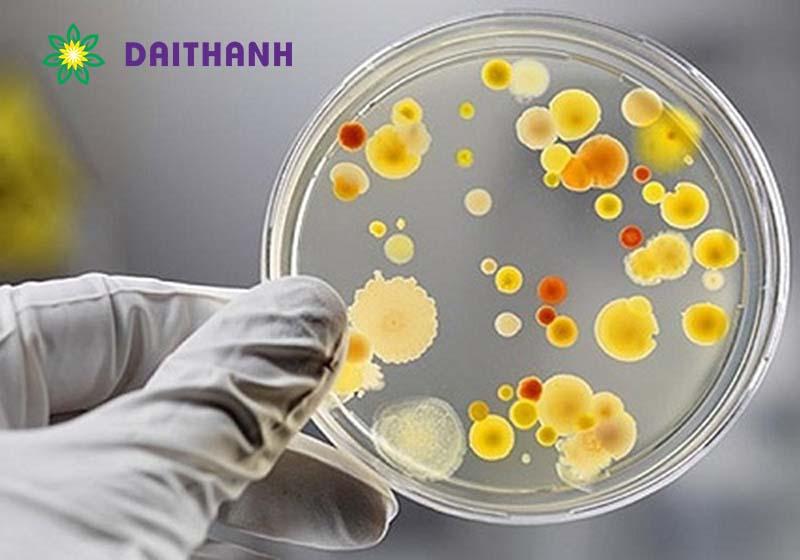
Công nghệ vi sinh là gì? 5 ứng dụng tốt & an toàn nhất trong nông nghiệp

Đáp án đề thi môn Lịch sử mã đề 305 kỳ thi THPT Quốc gia 2022
Đáp án đề thi môn Lịch sử mã đề 305 kỳ thi THPT Quốc gia 2022 đã được cập nhật đầy đủ nhất, chính xác nhất để các thí sinh có thể tiện tra cứu. Đáp án môn Lịch sử...
Top 5 sản phẩm nên dùng khi chăm sóc da sau peel
Da sau khi peel được chăm sóc đúng cách sẽ trở nên sáng mịn hơn. Ngược lại, khi da sau khi peel không được chăm sóc đúng cách sẽ tổn thương trầm trọng hơn. Vậy cách chăm sóc da sau...
Ferrous
Iron(II) chloride tetrahydrate, FeCl2·4H2O. In chemistry, iron(II) refers to the element iron in its +2 oxidation state. The adjective ferrous or the prefix ferro- is often used to specify such compounds, as in ferrous chloride for iron(II) chloride (FeCl2). The...
Liên Xô và các nước Đông Âu từ năm 1945 đến giữa những năm 70
I. Liên Xô và các nước Đông Âu từ năm 1945 đến giữa những năm 701. Liên Xôa. Công cuộc khôi phục kinh tế (1945 - 1950) * Bối cảnh: Liên Xô bị tổn thất nặng nề sau CTTG II...
Lý thuyết Hàm số bậc nhất y = ax + b (a ≠ 0) SGK Toán 8 - Chân trời sáng tạo
1. Hàm số bậc nhấtKhái niệm: Hàm số bậc nhất là hàm số được cho bởi công thức y = ax + b với a, b là các số cho trước và a khác 0.Ví dụ: y = 2x -...
Những dạng bài tập Toán lớp 4 đặc trưng từ cơ bản đến nâng cao
Trong chương trình học toán tiểu học, kiến thức học của học sinh lớp 4 là “nặng” nhất, có nhiều dạng toán đòi hỏi tư duy cao. Chính vì thế khi học, các bé cần rèn luyện thường xuyên bằng...
Hình bình hành
Hình bình hành Hình bình hành trong hình học Euclid là một hình tứ giác được tạo thành khi hai cặp đường thẳng song song cắt nhau. Nó là một dạng đặc biệt của hình thang gồm 4 góc và...
How to Stop a Dog From Barking at Strangers
For this Brentwood Dog Training session we worked with 1 year-old Pekingese Charlie, sharing tips to stop a dog from barking at strangers. Knowing that Charlie was primarily an indoor dog who did not go to puppy classes and lives...
Phương trình đưa được về dạng ax + b = 0
Chuyên đề Toán học lớp 8: Phương trình đưa được về dạng ax + b = 0 tổng hợp lý thuyết cơ bản Phương trình đưa được về dạng ax + b = 0, bên cạnh đó là các ví...
Lý thuyết về thấu kính mỏng
LÝ THUYẾT VỀ THẤU KÍNH MỎNGThấu kính là một khối chất trong suốt giới hạn bởi hai mặt cầu hoặc một mặt phẳng và một mặt cầu.Có 2 loại:- Thấu kính rìa (mép) mỏng:- Thấu kính rìa (mép) dày:- Trong...
Công nghệ vi sinh là gì? 5 ứng dụng tốt & an toàn nhất trong nông nghiệp
Công nghệ vi sinh là một lĩnh vực được ứng dụng rộng rãi trong nhiều lĩnh vực, đặc biệt là trong ngành nông nghiệp. Nó bao gồm việc sử dụng vi sinh vật để cải thiện sức khỏe đất, cây...
Photo Safari Report: Bespoke Two Valleys | Jul/Aug 2023
I was excited to lead this predator-focused safari during the dry months which is the best predator time in Zambia. We chose 3 camps in two national parks, hoping that the extended time would yield great rewards. Read on to...
Một hạt bụi nhỏ có khối lượng m = 0,1 mg, nằm lơ lửng trong điện trường giữa hai bản
Giải SBT Lí 11 Bài 5. Điện thế. Hiệu điện thế Bài 5.6 trang 12 Sách bài tập Vật lí 11: Một hạt bụi nhỏ có khối lượng m = 0,1 mg, nằm lơ lửng trong điện trường giữa hai...
Tích vô hướng
Tích vô hướng hình học, định nghĩa bởi góc. Tích vô hướng (tên tiếng Anh: dot product hoặc scalar product) là một phép toán đại số lấy hai chuỗi số có độ dài bằng nhau (thường là các vectơ tọa...